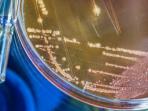

TAG
Dompu
-
Bripda Alvian Maulana berhasil diringkus tim yang dipimpin Kasat Reskrim Polres Indramayu AKP Muchammad Arwin Bachar.
7 hari lalu
-
Bripda Alvian Maulana Sinaga adalah terduga pelaku pembunuhan terhadap Putri Apriyani (21).
7 hari lalu
-
Akhirnya Biprda Alvian oknum polisi terduga pelaku pembunuhan Putri Apriyani tertangkap di Kecamatan Hu'u, Kabupaten Dompu, Nusa Tenggara Barat (NTB)
Minggu, 24 Agustus 2025
-
Seorang suami tega membunuh istrinya sendiri yang dipicu oleh persoalan utang. Nahasnya ia harus meninggalkan dua anak, salah satunya bayi 10 hari.
Senin, 9 Juni 2025
-
Seorang wanita 55 tahun ditemukan meninggal di kebun, sempat hilang 3 hari seusai tolak lamaran pria ke putrinya.
Rabu, 13 Oktober 2021
-
Seorang ibu ditemukan meninggal di kebun setelah sebelumnya mengaku tak setuju anak gadisnya dilamar seorang pria.
Selasa, 12 Oktober 2021
-
Pergi meninggalkan rumah setelah mengaku tak setuju anak gadisnya dilamar, seorang ibu di Dompu, NTB ditemukan meninggal dunia
Selasa, 12 Oktober 2021
-
Seorang ibu di Dompu, Nusa Tenggara Barat (NTB) pergi meninggalkan rumahnya diduga karena tak setuju anak gadisnya dilamar
Senin, 11 Oktober 2021
-
Seorang nenek berusia 87 tahun diperkosa sampai pingsan di Dompu, Nusa Tenggara Barat (NTB).
Sabtu, 7 Desember 2019
-
Seorang nenek berusia 87 tahun diperkosa sampai pingsan. Aksi pelaku tepergok cucu korban yang hendak mengantarkan makan siang korban.
Jumat, 6 Desember 2019
-
Dimarahi Ibunya, Siswi SMA Nekat Minum Racun Serangga Dicampur Teh. Kejadian ini bikin geger.
Jumat, 25 Januari 2019
-
Lokasi pusat gempa bumi berada di 8,23 lintang selatan - 117.86 bujur timur.
Senin, 1 Agustus 2016
© 2025 TRIBUNnews.com Network,a subsidiary of KG Media.
All Right Reserved